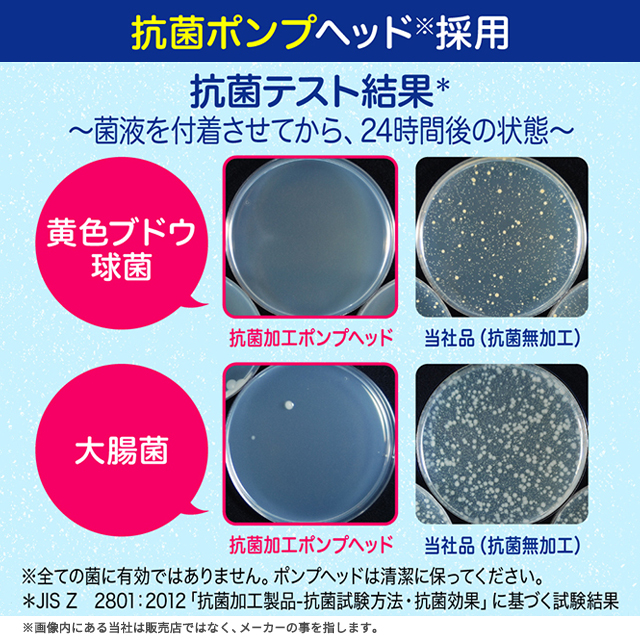

[4種類から1セット選択] ビオレu 泡ハンドソープ つめかえ用 770mL×4個セット 詰め替え 医薬部外品 花王
(6件)
Pontaパス特典
サンキュー配送
2,800円(税込)
0ポイント(1%)
商品説明
※同じ種類を4個お届けします。4種類から1つお選びください。・殺菌成分配合。
・汚れ、ウイルス・細菌を除去。
・素肌とおなじ弱酸性
・SPT(肌清浄化技術)採用。
・カサつきがちな手肌も、うるおいを守って洗えます。
<4種展開>
・手に香りが残りにくく、すっきりとしたマイルドシトラスの香り
・すすいだ後もほのかに残る、フルーツの香り
・手に香りが残らない、無香性タイプ
・ふわっと包み込まれるようなやさしい金木犀の香り
ビオレ ハンドソープ 泡 殺菌成分配合 弱酸性 つめかえ 詰め替え 大容量 大サイズ 特大サイズ マイルドシトラスの香り フルーツの香り 無香性 金木犀の香り

- 商品詳細
商品名 ビオレu 泡ハンドソープ つめかえ用 770mL×4個セット【医薬部外品】 ブランド ビオレu メーカー 花王 バリエーション マイルドシトラスの香り770mL×4個セット、フルーツの香り770mL×4個セット、無香性770mL×4個セット、金木犀の香り770mL×4個セット 容量 770mL×4個 成分 【マイルドシトラスの香り、フルーツの香り、金木犀の香り】
イソプロピルメチルフェノール*、水、ポリオキシエチレンラウリルエーテル硫酸アンモニウム(1E.O.)液、PG、エタノール、PEG6000、POEラウリルエーテル酢酸、グリセリルエチルヘキシルエーテル、アクリルアミド・アクリル酸・塩化ジメチルジアリルアンモニウム共重合体液、塩化トリメチルアンモニオヒドロキシプロピルヒドロキシエチルセルロース、エデト酸塩、乳酸、水酸化ナトリウム液、安息香酸塩、香料 *は「有効成分」無表示は「その他の成分」
【無香性】
イソプロピルメチルフェノール*、水、ポリオキシエチレンラウリルエーテル硫酸アンモニウム(1E.O.)液、PG、エタノール、PEG6000、POEラウリルエーテル酢酸、グリセリルエチルヘキシルエーテル、アクリルアミド・アクリル酸・塩化ジメチルジアリルアンモニウム共重合体液、塩化トリメチルアンモニオヒドロキシプロピルヒドロキシエチルセルロース、エデト酸塩、乳酸、水酸化ナトリウム液、安息香酸塩 *は「有効成分」無表示は「その他の成分」生産国 日本 区分 医薬部外品
注意事項
※こちらは「ビオレu 泡ハンドソープ つめかえ用 770mL」の商品ページとなります。その他の商品画像は参考画像となります。
・飲み物ではありません。
・子供や認知症の方などの誤飲等を防ぐため、置き場所に注意してください。
・湿疹、皮フ炎(かぶれ、ただれ)等の皮フ障害のある時は使わない。
・かぶれ、刺激等の異常が出たら使用を中止し、皮フ科医へ相談する。使い続けると症状が悪化することがある。
・目に入った時は、すぐに充分洗い流す。
・お使いのモニターや端末により色の見え方が実際の商品と異なることがございますが、イメージ違いによる返品・交換は承ることができません。
・ご使用前に必ず、お届けした商品のラベルや注意書きをご確認ください。
・商品の改訂などにより、商品パッケージの記載内容と異なる場合があります。
■つめかえ方
●必ず「ビオレu泡ハンドソープ」(販売名 ビオレu Hg、ビオレu Hg-a、ビオレu Hg-n、ビオレu Hg-k)の使用済みポンプボトルにつめかえてください。
●他の容器にはつめかえないでください。
●使い切ってからつめかえて、他の製品や異なった製造番号のものが混ざらないようにしてください。泡にならない・ポンプが押せなくなります。
●つめかえ量は、ポンプボトルの「つめかえる時、これ以上液を入れない」の矢印の位置までにしてください。
●つめかえ前にポンプボトルの中とポンプ部分を水道水でよく洗い、水気を切ってください。ポンプ部分は逆さにして数回押し、ポンプ内に残った液も出し切ってください。
●つめかえ用ボトルは、強く持つと液が飛び出ることがあるので、注意してください。
●つめかえ後は必ずキャップをして保管してください。
●つめかえ後、このボトルの底の製造番号を控えておいてください。お問い合わせの際に必要な場合があります。
●衛生的にお使いいただくために、4〜5回つめかえた後には、新しいポンプボトルにお取替えいただくことをおすすめします。
注記事項

レビュー
商品の評価:



4.2点(6件)
- お安く買えました
- まだまだ、コロナ、インフルエンザが流行っていますので、我が家には欠かせない、商品です。ありがとうございました。
- 良かったです
- 手が荒れにくく、ヌルつかないので、毎日、使ってます。
- よかった
- 毎日使用しています。量があるので心配せず使用でき購入してよかった
- ストックに
- いつも使っているハンドソープ、安く買えて助かりました。
- とても良いです。
- とても良い商品でした。 お得感も凄かありましてまた、購入したいです。
すべて見る
お店の情報
お店の評価:



-点(0件)
連絡・応対
-
配送スピード
-
梱包
-









